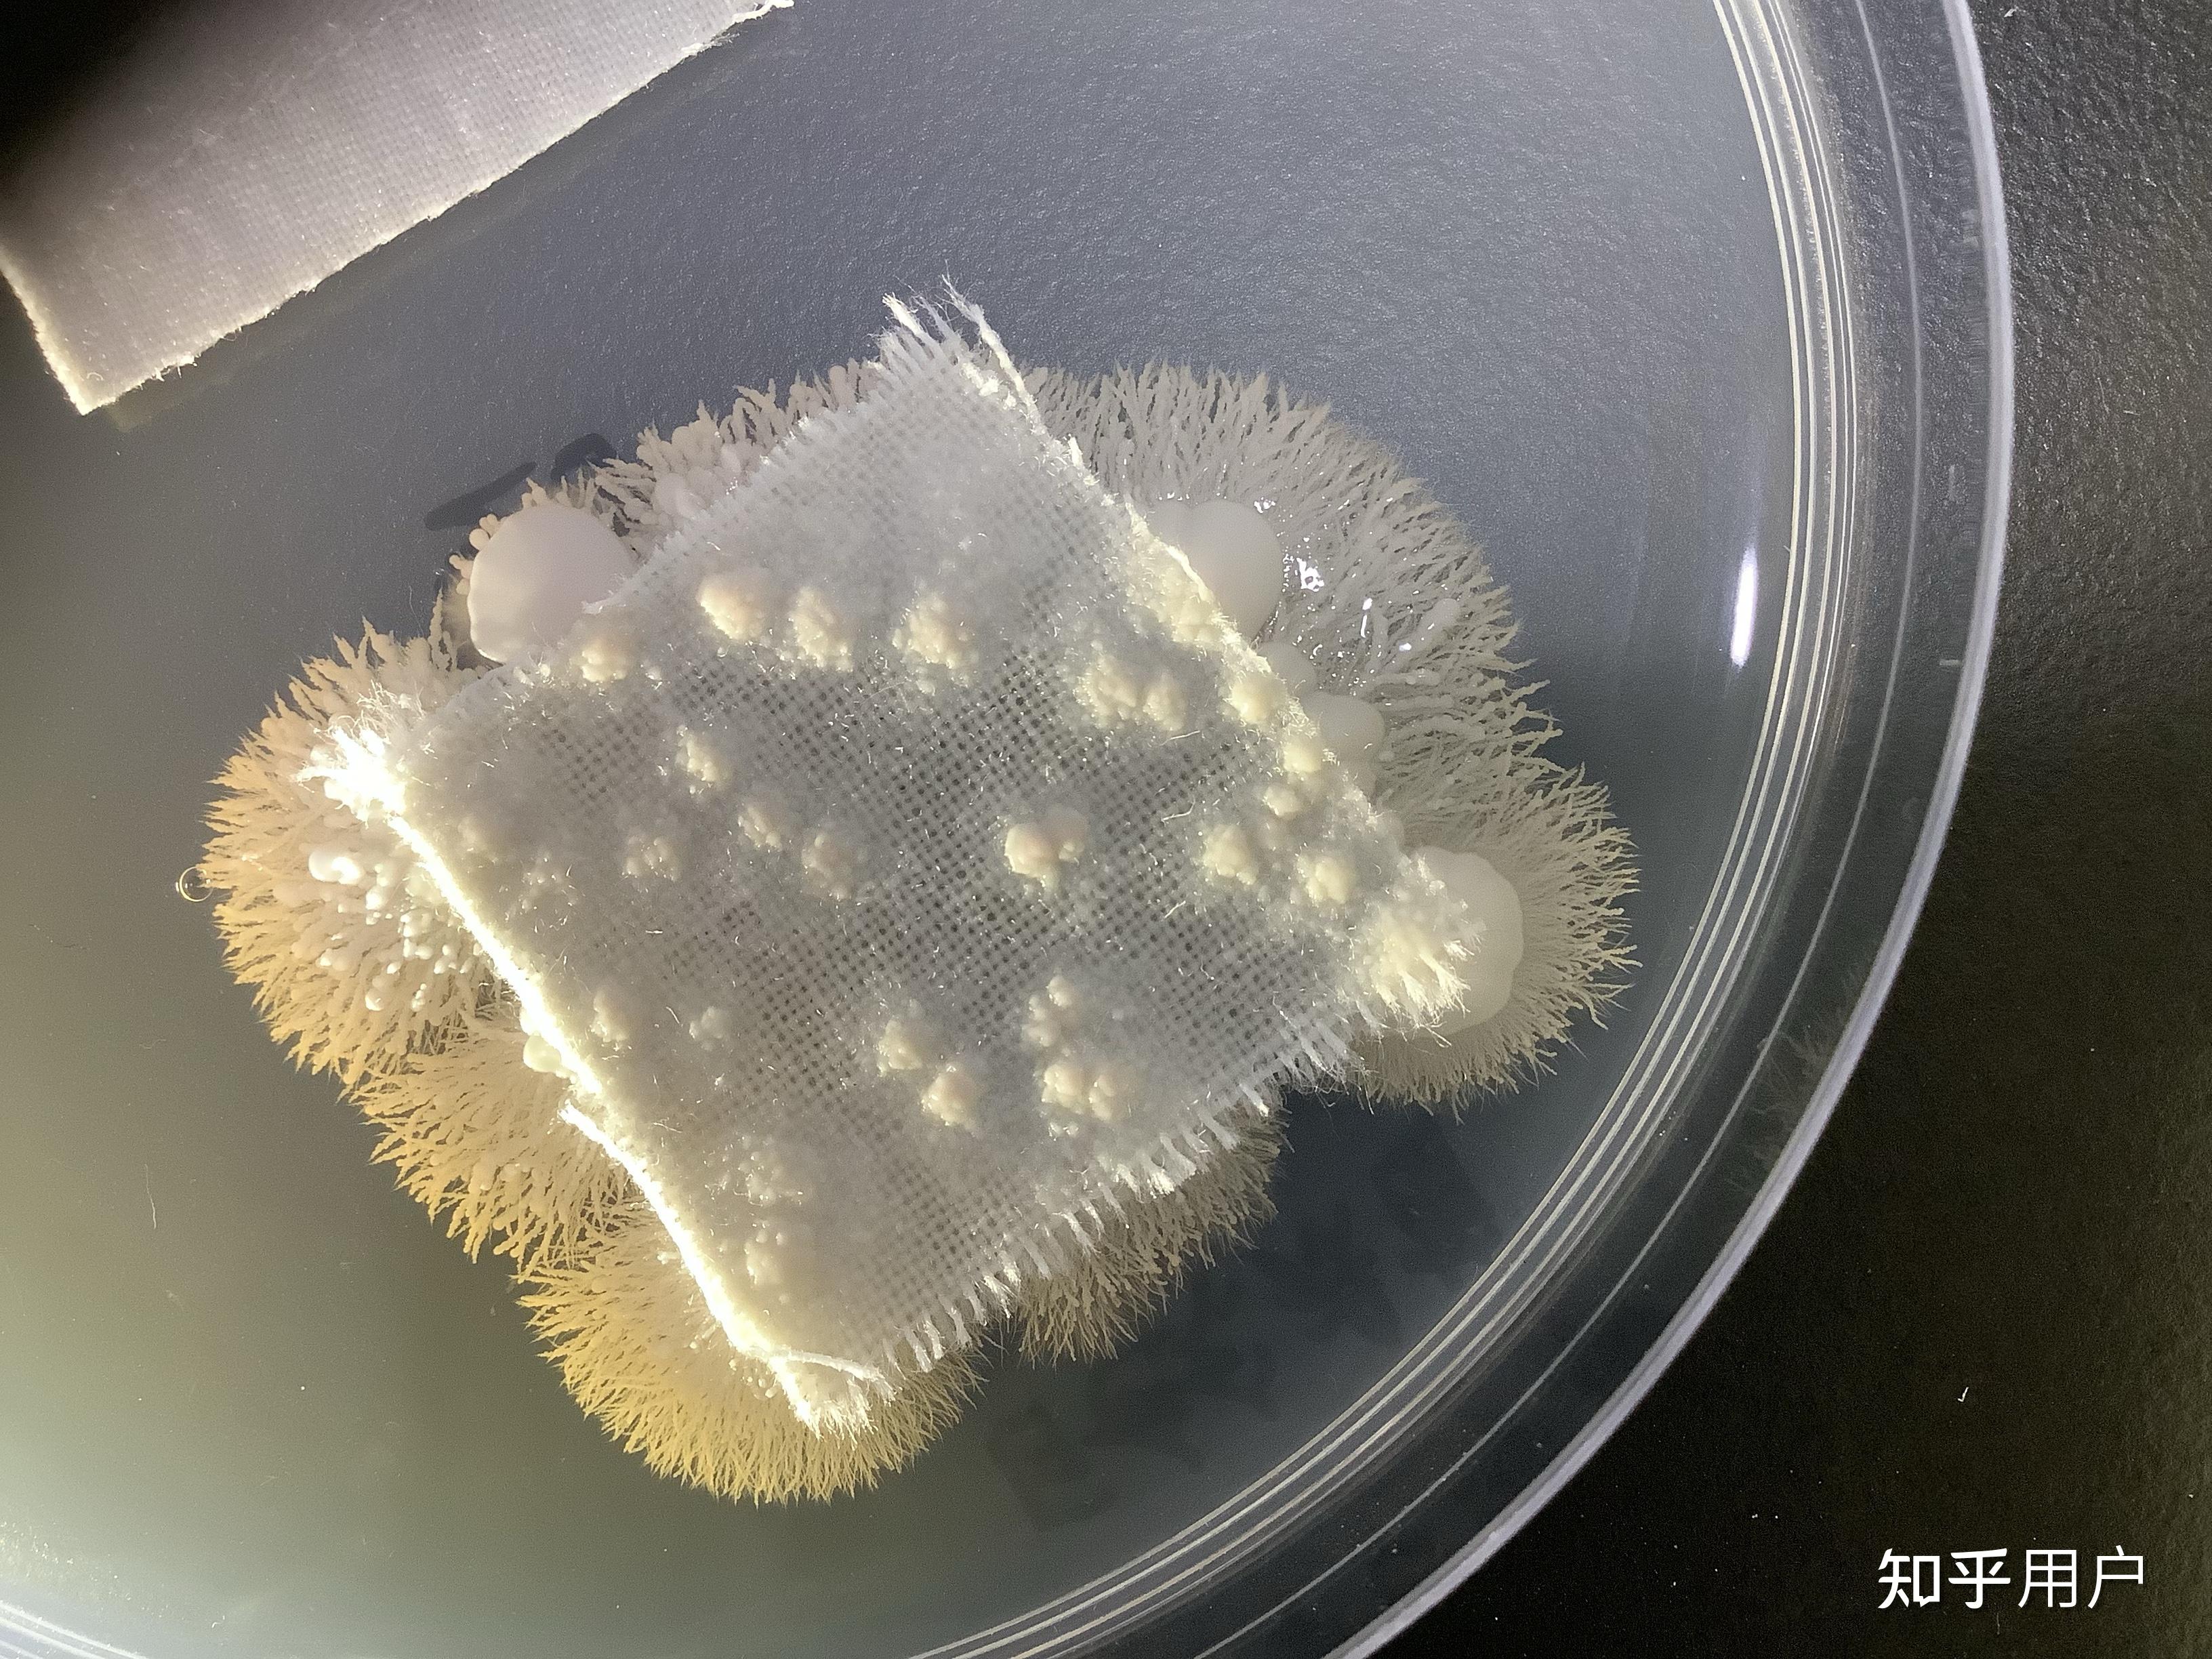
造成脚气的真菌,如果放在培养皿上培养,会变成蘑菇或肉眼可见的东西吗

脚气真菌显微镜图图

脚气可没你想的那么简单
图片尺寸700x474
显微镜下真菌菌丝,孢子
图片尺寸682x512
脚气,学名足癣,多由浅表性真菌中的皮肤癣菌引起,多为红色毛癣菌,须癣
图片尺寸883x662
《8种致病真菌在5种材料上的存活时间研究实验》这是显微镜下的真菌
图片尺寸1080x1342
显微镜下的霉菌
图片尺寸2667x2000
导致脚气和灰指甲的小坏蛋每晚都在悄悄吃你
图片尺寸1080x709
不管是脚气还是猫癣,狗癣,都是真菌感染导致的皮肤癣问题.
图片尺寸2667x2000
这取决于角度——当研究人员将导致瘙痒感染的真菌放在显微镜下观察时
图片尺寸553x422
荧光染液染色固定1-2分钟后,轻压盖玻片后在荧光显微镜下低倍镜观察
图片尺寸1080x1132
(真菌菌丝)敲黑板:脚气是病,得治!
图片尺寸640x551
生活小常识之脚气 - 季节 - 季节
图片尺寸300x200
在显微镜下皮癣真菌的菌丝结构.
图片尺寸640x853
160倍显微镜下的脚底死皮!
图片尺寸640x360
造成脚气的真菌,如果放在培养皿上培养,会变成蘑菇或肉眼可见的东西吗
图片尺寸720x898
通过从"脚气"患者足部分离,用显微镜观察,培养,并鉴定致病真菌的方式
图片尺寸660x446
关于脚气之脚气的形成
图片尺寸1440x1080
看看上图中霉豆腐上的霉菌和显微镜下足癣的菌丝是不是很像,再看下图
图片尺寸1080x1439
造成脚气的真菌,如果放在培养皿上培养,会变成蘑菇或肉眼可见的东西吗
图片尺寸3264x2448
男子被鱼刺扎了一下右手差点保不住年年有人中招
图片尺寸280x208
真菌感染引起的足癣种类多,症状也不同,及时治疗是关键!
图片尺寸640x427